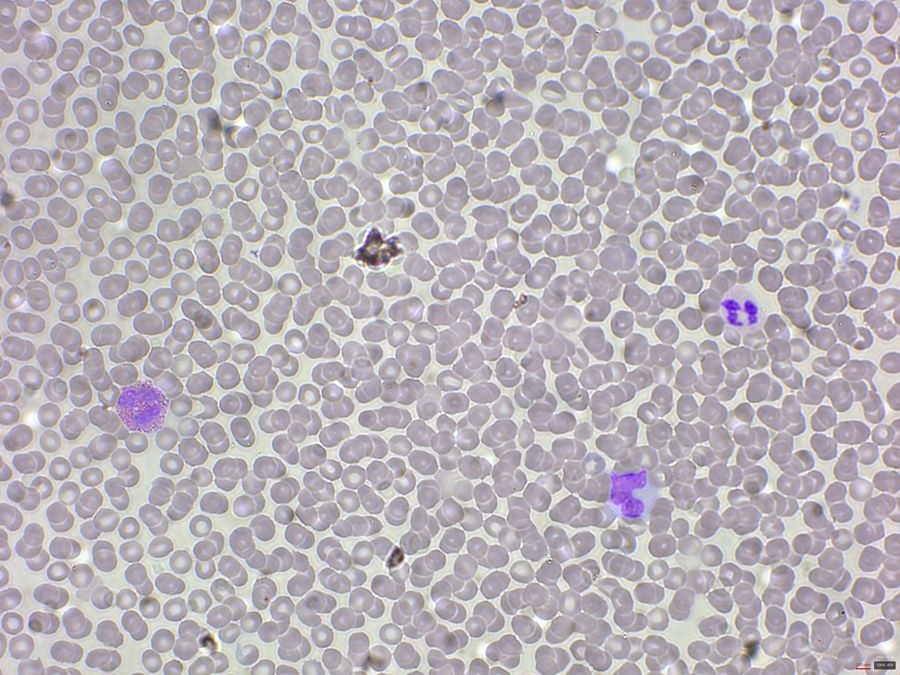
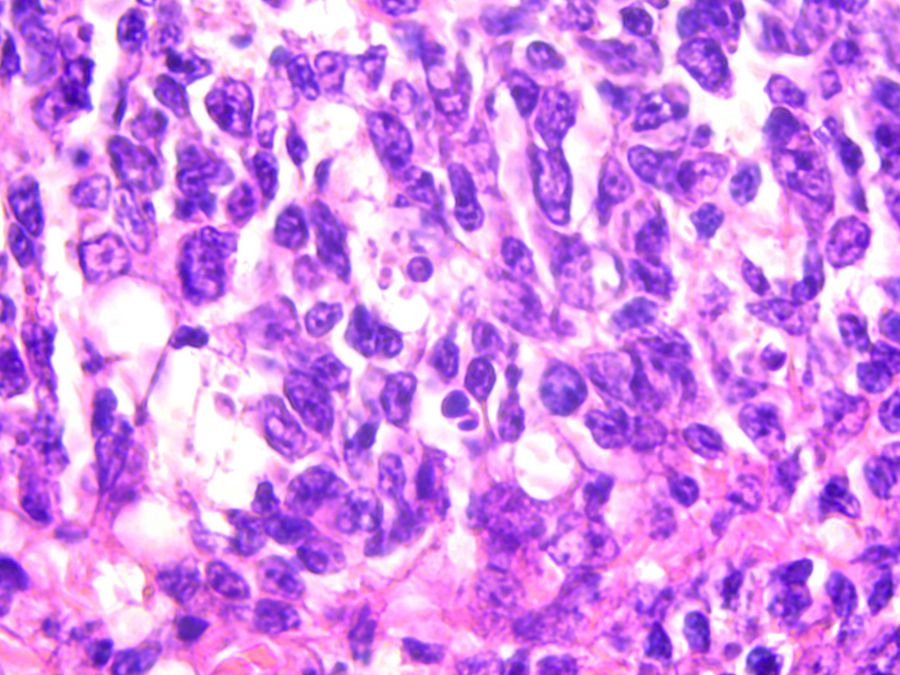

Clinical Pathology Microscopy Solutions by Leica Microsystems
Clinical microscopy offers crucial diagnostic and research insights across diverse medical fields like hematology, urinalysis, and histopathology.
Leica clinical microscopes offer the clarity and precision essential for reliable diagnosis of pathology samples, including tissue, urine, blood, and sperm. Pathologists appreciate the optical quality and ergonomic design of our microscopes.
Designed for enhanced efficiency and comfort, our microscopes feature ergonomic accessories, high-quality optics, and true-color cameras. This ensures comfortable posture, optimal hand positioning, and reduced strain through symmetrically laid out adjustable stage and focus controls. You'll also benefit from balanced light intensity to minimize eyestrain, alongside an efficient workflow with minimal repetitive motions and fast objective changes via toggle mode.
Your local Leica team can help you find the right microscope. Contact us today and get 15% off your first order! *
To receive your personal discount, please read our Terms and Conditions and simply fill out the contact form!*
15% Discount
How Microscopy Drives Hematologic Diagnosis
Microscopy plays a pivotal role by enabling the visualization of blood smears and bone marrow aspirates, aiding in the identification of abnormalities, such as anemia, leukemia, and clotting disorders. This microscopic analysis provides important insights into hematologic conditions, guiding diagnosis, treatment decisions, and monitoring of patient responses to therapy.

Precision in Histopathology
For the histopathologist, the microscope is the essential tool for tissue visualization, helping with identification of cellular and tissue-level changes that are the very signature of disease.
Microscopy in Cytopathology: Integral to Early Detection
In cytopathology, the microscope represents the primary gateway to understanding cellular changes, enabling cytopathologists to precisely visualize and interpret individual cells, clusters, and their intricate arrangements. This direct, high-resolution cellular analysis is fundamental for the early detection, accurate diagnosis, and effective management of a broad spectrum of diseases, often with minimal patient invasiveness.
Meet the new Visoria B laboratory microscope
Use the Visoria B laboratory microscope for various types of life science studies, including human and animal histology, plant anatomy, and pathology examinations.
- Reveal sub-cellular structures in tissues and specimens with various contrast methods, such as brightfield, darkfield, phase contrast, DIC, and four-color fluorescence.
- Visoria B is also certified for in -vitro diagnostics (IVD).

*Terms and Conditions
- This offer is only valid for new customers (no orders within the last 3 years)
- Offer expires December 31st, 2026, and can be applied to orders placed up until this date.
- This offer cannot be used in conjunction with any other promotion or discount, is subject to availability and may be withdrawn at any time
- For all other countries in the EMEA region, please check with your local Leica partner about the availability of this promotion.
- Valid for the following countries: Austria, Germany, Switzerland, Spain, Italy, Belgium, Luxembourg, Portugal, the Netherlands, United Kingdom & France.
- All other countries in the EMEA region: Please check with your local Leica partner about the availability of this promotion.
